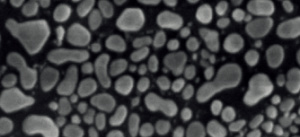
3.png

麦克奥迪 Easy Nanoscan 系列桌面式扫描电子显微镜,拥有超高分辨率,将桌面式电镜的分辨率提高到 5nm 的水平,可与传统大型扫描电镜相媲美。Easy Nanoscan 同时具备多种探测模式,包括二次电子、背散射电子和能谱分析,将桌面式扫描电镜对样品进行表面形貌分析、元素分析以及两者相结合的技术充分应用到工业和科学研究领域中。
全国服务热线:0512-6603 8633
在线咨询EasyNanoScan
多功能桌面式扫描电镜
高分辨率 | 完全集成 EDS | SE&BSE 合成像 | 全新分析软件

关于 Motic
麦克奥迪实业集团有限公司始创于 1983 年,目前系北京亦庄投资控股有限公司混改所有制企业、深证交易所创业板上市公司麦克奥迪(厦门)电气股份有限公司(证券代码:300341,证券简称:麦克奥迪)全资控股的企业集团。主要从事光学显微镜的研发、生产和销售,主要产品以数码显微镜、显微图像集成系统和自动显微镜为代表。三大类型产品包含近百个型号,主要包括 MOTIC、SWIFT、NATIONAL、CLASSICA 等品牌。麦克奥迪是长期耕植于国内光学显微镜领域的专业企业,产品品牌在全球光学显微镜领域属于主要品牌之一。具备零部件、整机和成套系统的制造能力,构建产品全球营销网络,主要面向基础教育、高等教育、科学研究、工业和生物医药等领域。目前产品销往全球 130 多个国家和地区,客户遍及国内、中国香港、中国台湾,西班牙、日本、德国、美国、加拿大、澳大利亚、韩国和沙特阿拉伯等国家和地区。多年来,麦克奥迪一直致力于显微系统的改进和创新,帮助各行各业的检测人员实现检测手段的不断进步和提升。
EasyNanoScan 多功能桌面式扫描电镜
麦克奥迪 Easy Nanoscan 系列桌面式扫描电子显微镜,拥有超高分辨率,将桌面式电镜的分辨率提高到 5nm 的水平,可与传统大型扫描电镜相媲美。Easy Nanoscan 同时具备多种探测模式,包括二次电子、背散射电子和能谱分析,将桌面式扫描电镜对样品进行表面
形貌分析、元素分析以及两者相结合的技术充分应用到工业和科学研究领域中。
产品特点
高分辨率(5nm@30KV(SE) 10nm@30KV(BSE);
放大倍数 ×200,000;
全新升级的分析软件,舒适通用;
自动马达台;
可同时采集二次电子和背散射电子图像;
CCD 样品导航
EasyNanoScan 技术参数
成像系统 | |
分辨率 | 5nm@30kV(SE) 10nm@30kV(BSE) |
电子枪 | 预对中钨丝灯 |
探测器 | 标配 : 二次电子 (SE) 标配 : 背散射电子 (BSE) |
放大倍数 | 10X to 200,000X |
加速电压 | 1 to 30kV |
样品室 | |
工作距离 | 5 to 40mm |
载物台尺寸 | X,Y:40mm,Z:5~40mm, T: -90~90°(手动), R: 360°X,Y,Z(电动) |
最大样品尺寸 | 80mm(D)x40mm(H) |
导航模式 | 光学图像 |
真空系统 | |
时间 | 真空 :<90 秒 , 排气 :<10 秒 |
真空模式 | 高真空模式(< 9x10-3 Pa)/ 低真空模式 |
真空泵 | 电动阀系统(无需压缩机) 全自动真空系统 - 涡轮分子泵和旋转叶片泵 |
控制系统 | |
工作站 | 基于 Windows 11 的多合一 24" 屏幕工作站 |
显示模式 | 聚焦模式 : 320 x 240 像素 预览模式 : 800 x 600 像素 慢扫模式 : 适用于预览和对焦模式 图像模式 : 高达 3200 x 2400 |
图像格式 | JPEG,Tiff,BMP,PNG |
内置防振系统 | 选配 |
仓内相机 | 选配 |
元素分析 | 选配 |

EasyNanoScan 系列技术优势
高分辨率
EasyNanoScan 系列桌面式扫描电镜具有与任何常规 SEM一样的高性能分辨率 (×200K@30KV),图像表面信息更丰富细腻,可满足高校、科研院所、企业研发等研究领域样品表面的微结构和表面形貌的微观观察。
集合二次电子信息和背散射电子进行观察
EasyNanoScan 系列桌面式扫描电镜可标配 SE+ 可伸缩式 BSE 探测器,可实现对样品的元素衬度、形貌衬度分析,同时也可选配 EDS 探测器 ( 能谱仪 ),对材料所含元素种类及分布进行快速的定性及定量分析。

每个通道作为 (+) 或 (-) 共为 BSE 提供 24 成像组合

软件功能

新升级光学导航功能
光学导航实现快速准确样品定位与追溯。
全新的操作界面
SEM 软件操作界面简便,所有操作只需要点击鼠标就可以解决。
专业牛津 / 布鲁克能谱分析
能谱仪(EDS)主要是用来对材料微区元素组成进行定性、定量分析的一种科学仪器。广泛应用于各种材料的元素分析,如金属、陶瓷、混凝土、矿物、生物等无机或者有机固体材料分析等。
EasyNanoScan 系列桌面式扫描电镜可与 OXFORD(牛津)等主流能谱仪厂家合作,有针对性的满足客户的需求。

EasyNanoScan 附属设备
利用冷台可将样品冷冻到 -20℃,并在低真空模式下进行分析,不破坏样品本身的形貌,即可实现观察与分析。特别适用于含水分高的食物、生物组织、易受热损伤的样品的观察。在同一冷台上不仅可以放置冷冻样品,还可以放置常温样品。安装方便,设计紧凑,节省空间。( 正在申请美国专利 16/287,770)

尺寸 :30x20x23(H)cm, 5kg / 温度范围 :-20° C~+50° C/ 冷却速率 :30° C 每分钟

离子镀膜仪
在样品上快速镀金和铂
通过增加导电性来增加图像的对比度和亮度。离子溅射镀膜仪可在样品上形成一层薄的金属膜,以获得更好的导电性。
• 适合任何地方的现代金属设计
• 磁控溅射技术
• 简单的触摸屏操作


EasyNanoScan 应用领域
材料科学

生命科学

能源

半导体与电子




微信二维码
网站二维码